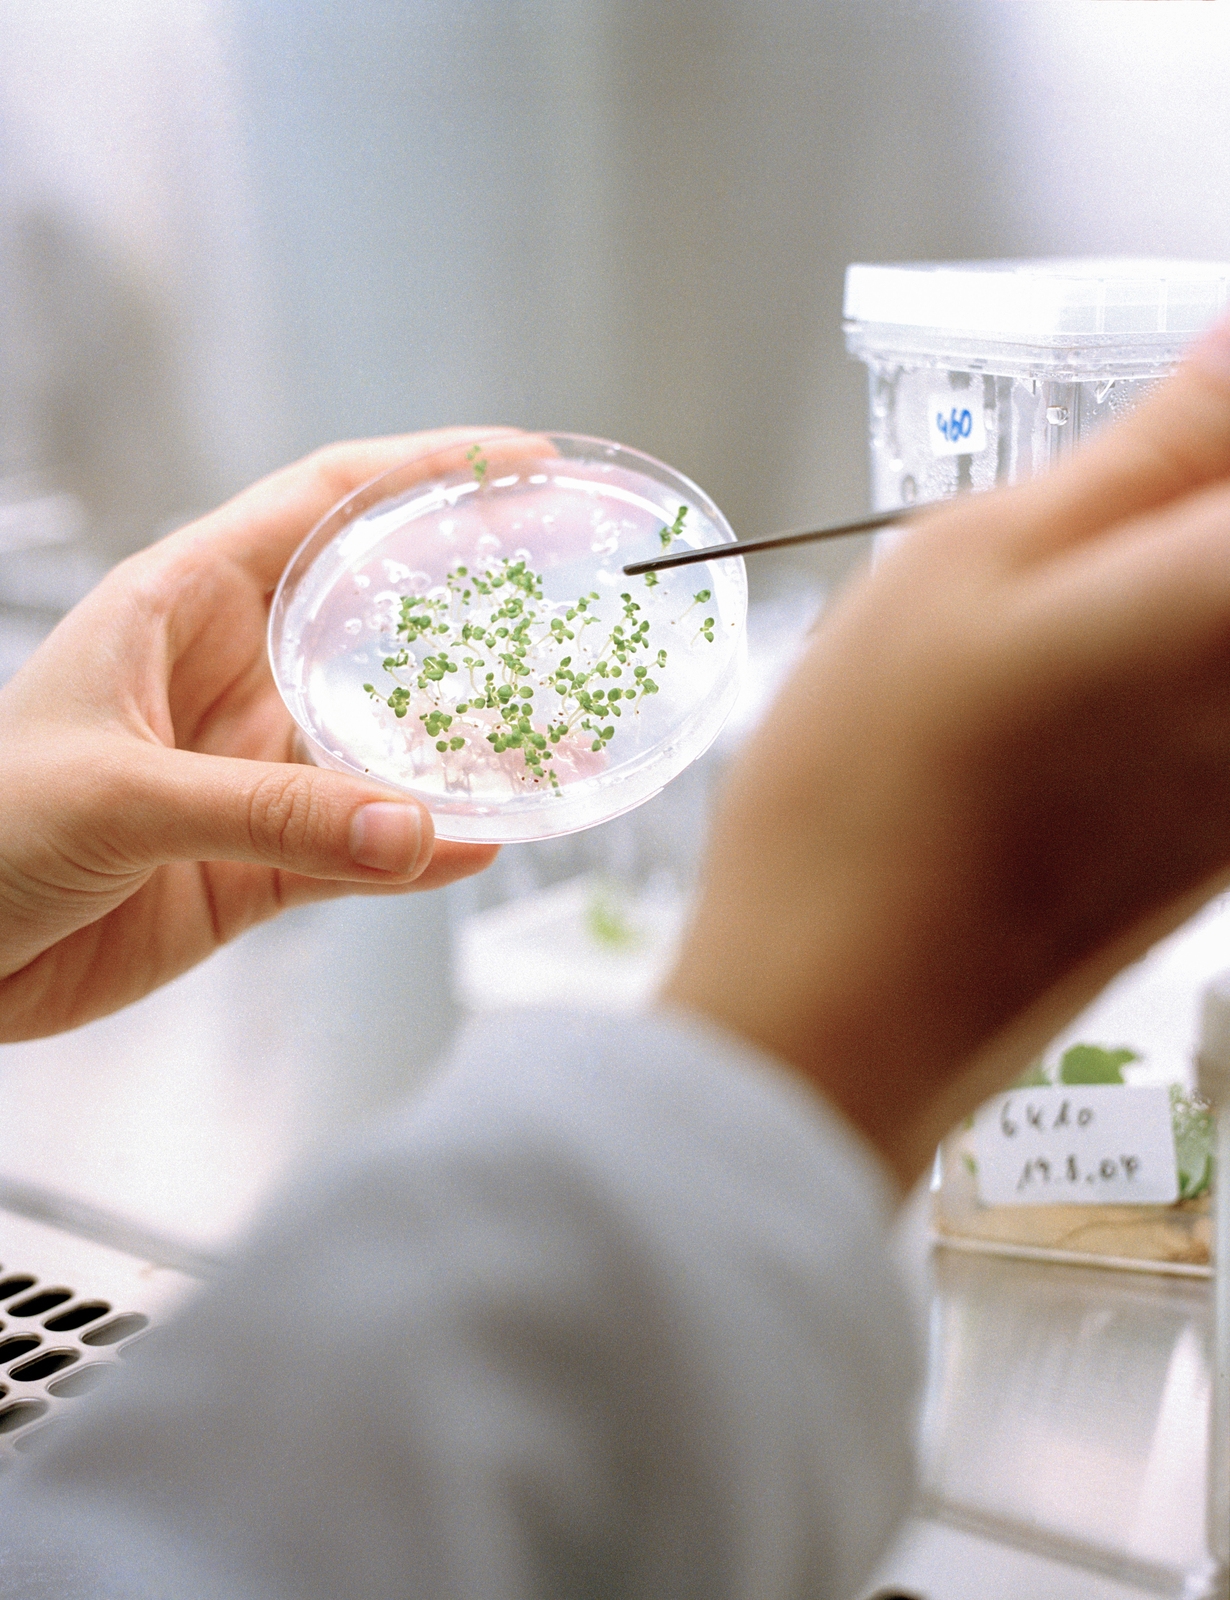

Det finns väldigt många inriktningar att välja bland för dig som vill bli biolog. Vad du arbetar med beror till stor del på vad du väljer:
* En del biologer har kunskap om arter och släktskap mellan olika växter eller djur som sin specialitet.
* En fysiolog har specialkunskaper om hur växter, djur eller människor fungerar.
* Ekologen har fördjupat sig i studier om hur de levande organismerna samspelar med sin miljö.
Marinbiologen är expert på livet i havet medan en limnolog har motsvarande kunskaper om sötvattenmiljöer. Ekologer, marinbiologer och limnologer kan ofta arbeta inom offentlig förvaltning med till exempel miljöfrågor. De kan även jobba på olika konsultföretag med miljöutredningar.
Mikrobiologen är specialist på mikroorganismer, det vill säga bakterier, virus och mikrosvampar. Mikrobiologer arbetar bland annat inom industrin, vid sjukhuslaboratorier eller vid universitet och högskolor. Inom livsmedelsindustrin kan mikrobiologen till exempel delta i produktutveckling eller arbeta med hygienkontroll av råvaror och produkter. En mikrobiolog inom sjukvården analyserar prover från människor för att se vilka infektionssjukdomar de har. Inom den biotekniska industrin deltar mikrobiologen i utvecklingen av bakterier som kan tillverka värdefulla substanser, till exempel insulin för den som har diabetes.
Molekylärbiologer arbetar med de allra minsta beståndsdelarna i de levande organismerna. De kan till exempel studera vilken funktion olika delar av arvsmassan, DNA, har vid uppkomsten av sjukdomar. Målet kan vara att utveckla nya läkemedel. De flesta molekylärbiologer arbetar med forskning och utveckling, till exempel inom universitetsvärlden eller läkemedels- och bioteknikindustrin. Molekylärbiologen kan själv arbeta praktiskt i laboratoriet eller vara ansvarig för forskningsprojekt och samordna arbetet.
Exempel på andra specialiseringar du kan ha som biolog är etolog, entomolog och genetiker. Etologen är specialist på djurs beteende, entomologen är expert på insekter och genetikern studerar hur arvsanlag är uppbyggda och ärvs från en generation till nästa. En cellbiolog har fördjupade kunskaper om hur celler är uppbyggda och fungerar. Även cellbiologens och genetikerns kunskaper är intressanta för till exempel läkemedelsindustrin. Genetiker finns också inom växtförädlingsområdet.
Som biolog kan du också bredda din utbildning och komplettera med bland annat pedagogik för att bli behörig lärare. Näraliggande ämnen kan till exempel vara kemi och geovetenskap.
Det finns alltså många olika inriktningar inom biologin men gränserna är inte skarpa mellan de olika områdena. Inom området bioteknik knyts kunskapsområdena biologi, kemi, medicin och teknik samman och mynnar ut i tekniska tillämpningar av biologisk kunskap. Kopplingen mellan ämnesområdena gör att det finns alternativa vägar mot arbete med bioteknik. Till exempel kan en civilingenjör ha inriktning mot bioteknik eller molekylärbiologi i sin utbildning, precis som en biolog kan ha det. En biotekniker kan bland annat arbeta med produktutveckling inom läkemedels- eller livsmedelsindustrin, eller trä- och pappersindustrin. Forskning är ett annat område där biotekniker finns.
Bioinformatik är ett annat område där biologi ingår som en viktig del. En bioinformatikers uppgift kan vara att analysera den stora mängd information som finns om människans arvsmassa, DNA. Kunskaper i datavetenskap och matematik är viktiga för en bioinformatiker. Genom datorbearbetning av stora mängder biologiska data öppnas nya möjligheter att till exempel utveckla mer effektiva läkemedel. Även här kan du till exempel vara biolog eller civilingenjör med specialisering mot området. Bioinformatiker efterfrågas bland annat av läkemedels- och bioteknikföretag. De kan också arbeta med forskning inom universiteten.
Ett annat område som hör ihop med biologin är biomedicin. I biomedicinarutbildningen ligger tyngdpunkten på molekylärbiologi kopplat till kunskaper om människan och sjukdomar. Biomedicinare kan arbeta inom medicinsk forskning, inom hälso- och sjukvården och inom läkemedels- och bioteknikindustrin.
Toxikologer undersöker, bedömer och informerar om hur olika kemiska ämnen påverkar människor, andra levande organismer och den miljö de lever i. Det kan till exempel gälla miljöföroreningar som gör att fiskar får svårt att fortplanta sig eller ämnen i maten som orsakar sjukdomar eller andra skadliga effekter hos människan.